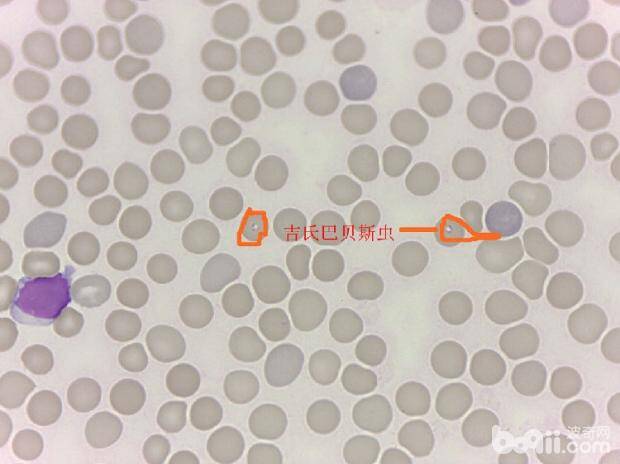

比格犬呕吐的原因及治疗办法

比格犬(详情介绍)
临床研究发现,导致比格犬呕吐的原因有几种,而且不同原因造成的呕吐后果也不一样。当然,在宠物狗有呕吐行为的时候,作为主人应该能大致的判断是何原因造成的,然后在及时的给与处理和治疗,以确保比格犬身体健康。
引起比格犬呕吐的第一个原因:
有时候比格犬就是一个"吃货",对食物都有一种贪婪的欲望。然而因为狗狗根本不懂得细嚼慢咽这个道理,所以狼吞虎咽的后果必然是肠胃不消化。为此,在比格犬吃完东西之后,就会发生呕吐的行为。
然而,这种情况家长不用太担心,这种情形下,比格犬呕吐物多半为刚吃下去的食物,而且狗狗在呕吐完之后会将这些食物在吃回去(如果不想让狗狗吃,那么一定要第一时间处理掉哦),等过了几个小时,比格犬完全消化了这些食物之后,就没有什么问题了。或者可以给比格犬吃一些有助于肠胃消化的药片,帮助其肠胃消化。
引起比格犬呕吐的第二个原因:
在比格犬呕吐之后,要确定原因,首先应该仔细观察狗狗的呕吐物。如果呕吐物是带泡泡的黄水,并且有臭臭的味道,那么这多半是由于胃炎引起的。对于这样的比格犬,应该立即停食观察,可以供应适量的饮水。胃炎不是一个小病,家长们还应该将比格犬及时的送往医院救治。
引起比格犬呕吐的第三个原因
当比格犬不小心被鱼刺、鸡骨头掐住的时候,也会有呕吐的行为。此时的比格犬会表现得不舒适,用爪子抓嘴和牙齿,会呕吐不止。如果比格犬真的不幸被鱼刺、鸡骨头掐住,家长不要随便自己伸手去狗狗口中拔刺,还是应该送比格犬去医院,请兽医帮忙。同时,还要彻底检查,看看比格犬喉咙、肠胃是否有被鱼刺、鸡骨头刺伤,然后进行专业的治疗。
值得注意的是,除了以上原因会导致比格犬呕吐之外,犬瘟、狂犬病、食物中毒等等,都会导致狗狗有呕吐的情况。作为主人应该注意,如果狗狗除了呕吐,还有其它异常病症,如癫痫、流脓鼻涕、吐血、呕吐白沫、会疯狂的扑咬人时,家长一定要及时的控制住狗狗,然后送往医院治疗,千万不要无故拖延救治时间,造成无法挽救的后果。